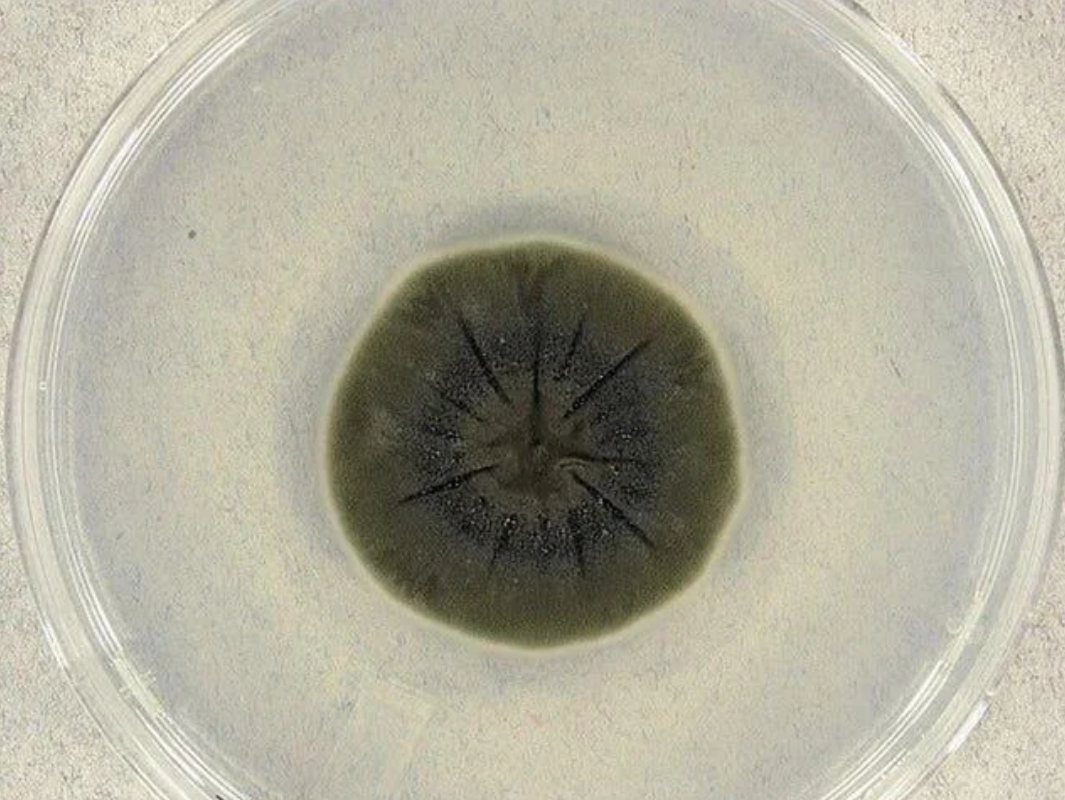

切尔诺贝利的真菌正在学会吸收强辐射 可能利用辐射进行未知的代谢
上面这张照片中黑色的部分,是一种生长在切尔诺贝利的真菌,您可能已经发现了它们生长非常规则,大量群落都生长在一个圆形的区域内。
之所以会这样,是因为这个圆形区域比周围拥有更强的辐射,而这些真菌群落在强辐射下生长得更好。
△ 切尔诺贝利事故区域
众所周知,1986年4月26日凌晨,切尔诺贝利核电站4号反应堆发生剧烈爆炸,导致大量放射性核素一次性释放,并溅射到周围环境中。
这些放射性核素会释放电离辐射,其能量远高于太阳光,能够轻松撕裂DNA和蛋白质,如果生物体长时间暴露在这种环境下,有可能会被杀死或者大大增加患癌风险。
为了防止辐射的影响,事故发生后,当局设立了一个直径 30 公里的禁区,禁止无关人员进入。
△ 切尔诺贝利禁区警示标识
有意思的是,随着人类的撤离,切尔诺贝利的生态开始恢复,包括狼、野猪在内的许多动物都开始回归“隔离区”,但是我们前面提到的那些真菌是唯一能够生活在辐射核心的生命。
那么问题是,为什么这些真菌能够在电离辐射中存活下来,并且似乎会向着辐射强烈的地区生长呢?
这些菌落其实是包含多种真菌的霉菌菌落,1997年的时候——也就是事故发生的第11年,例行进入隔离区调查的科学家就已经发现了它们。
这些霉菌占据了那些对生命有害的区域,所以在当时就引起了科学家的注意,并长期对它们进行了调查和研究。
其实,这些真菌能够在强烈的电离辐射中存活下来的关键因素之一就是黑色素!
您可能已经发现了,这些菌落是呈现黑色的,其实就是因为它们的细胞壁充满了黑色素。
黑色素是一种广泛存在于地球生物体内的色素,我们人类呈现出不同的肤色、发色等都是通过黑色素进行调节的。
就像皮肤更黑的人可以更好地保护自己免受紫外线辐射影响一样,这些黑色的真菌也在利用黑色素来阻挡电离辐射对其的影响。
至于黑色素是如何阻挡辐射的?
这个其实不是我们理解的那种阻挡,而是黑色素的分子结构能够有效将紫外线的辐射或者放射性粒子吸收,然后将能量消散掉;
另一方面,黑色素还是一种抗氧化剂,它能够将辐射在生物体中产生的活性离子还原为稳定状态,从而进一步保护细胞免受辐射影响。
其实,在切尔诺贝利隔离区内,不仅是真菌表现出黑色素堆积,其他动物也都如此,比如切尔诺贝利的青蛙正在变成“黑蛙”。
△ 切尔诺贝利的树蛙肤色变得越来越黑,Germán Orizaola/Pablo Burraco
生物利用黑色素抵抗强辐射,这很好理解,但是为什么切尔诺贝利的这些真菌还会向着辐射强烈的地方生长呢,这不是增加生存难度吗?
切尔诺贝利真菌这种趋向辐射生长的情况被称为“向辐射性(radiotropic)”。
实际上2006年的一项研究指出,这些真菌不仅表现出向辐射性,其中一些还表现出在辐射存在的情况下加速生长。
主导2006年这项研究的科学家是,纽约阿尔伯特·爱因斯坦医学院的核科学家叶卡捷琳娜·达达乔娃(Ekaterina Dadachova),她认为这些真菌趋向辐射可能不仅仅为了取暖,更有可能是在主动吸收辐射能量完成生命活动,就像光合作用一样,她将这个生命过程称为"辐射合成(radiosynthesis)"。
不过,她的这一理论还没有找到实际证据,电离辐射的能量大约是光合作用所利用的白光能量的一百万倍,生物体要利用这种能量进行代谢是非常困难的,它们必须找到一种非常强大的“能量转换器”才行。
达达乔娃认为,黑色素可能就是在这种代谢过程中扮演了“能量转换器”的角色!
另外,她的团队目前也已经找到一些可能导致真菌在电离辐射下生长增加的途径和蛋白质。
但仅此而已,真菌在电离辐射下代谢的确切机制目前还不得而知,也不知道这个过程是否真的存在。
Smith Collection/Gado
最后
不管怎么样,这些真菌的存在,给清理放射性场地带来了希望。
不过,科学家对这类真菌设想的未来,不仅是它们清理放射性场地,有一些科学家真正试图利用这种真菌来保护宇航员在太空旅行中免受有害辐射的影响。
目前,从切尔诺贝利分离得到的球孢枝孢菌(Cladosporium sphaerospermum)已被证实能够在国际空间站上宇宙辐射环境中加速生长,并有效屏蔽宇宙辐射。
在地球上,我们其实有很多材料可以屏蔽辐射,最常用的就是水,但是任何这些材料想在太空活动中作为辐射防护层,它们都太重了,会大大增加发射成本。
而利用这些真菌作为防护层,不仅发射成本极低,而且它还是一种能够自我修复的屏障。
或许在不久的将来,这些在切尔诺贝利废墟中蔓延的真菌,真的能够保护我们在太阳系其他地方的新世界里迈出的第一步。